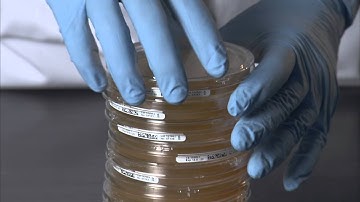
How to use the lockable ICRplus settle plate for air monitoring.

⬇ DOWNLOAD NOW
Jika muncul iklan pop-up, tutup lalu klik tombol kembali
Download lagu IsoBag™ Optimize Your Environmental Monitoring Workflow secara gratis hanya untuk keperluan promosi. Dukung artis favorit kamu dengan membeli musik original di iTunes atau platform resmi lainnya.
 Streamlining your Environmental Monitoring Workflow in SampleManager LIMS
Streamlining your Environmental Monitoring Workflow in SampleManager LIMS How to use the lockable ICRplus settle plate for air monitoring.
How to use the lockable ICRplus settle plate for air monitoring. OpreX Environmental Monitoring System (OpreX EMS) Concept Video
OpreX Environmental Monitoring System (OpreX EMS) Concept Video [PROPL'25] Spatial Programming for Environmental Monitoring
[PROPL'25] Spatial Programming for Environmental Monitoring Maintaining an effective environmental monitoring program - aseptic technique
Maintaining an effective environmental monitoring program - aseptic technique Why Smarthood?
Why Smarthood? The Importance of Environmental Monitoring in the Manufacturing Workspace
The Importance of Environmental Monitoring in the Manufacturing Workspace AI Predicts Soil Erosion Before It Happens | Smart Tech for Land Conservation
AI Predicts Soil Erosion Before It Happens | Smart Tech for Land Conservation